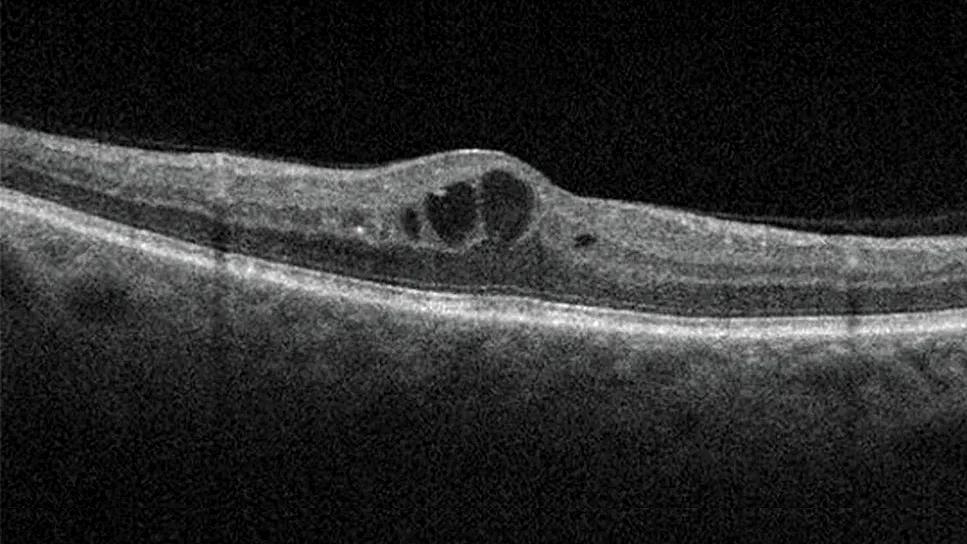

Less than 50% of patients with diabetes get appropriate ophthalmic screening through primary care referrals
Image content: This image is available to view online.
View image online (https://assets.clevelandclinic.org/transform/ee91788b-1b1a-468a-a55d-a0ab984b7239/diabetic-macular-edema-hero)
Diabetic macular edema
By David D. Chong, BA; Nikhil Das, MD; and Rishi P. Singh, MD
Advertisement
Cleveland Clinic is a non-profit academic medical center. Advertising on our site helps support our mission. We do not endorse non-Cleveland Clinic products or services. Policy
This article is reprinted from the August 2024 issue of Cleveland Clinic Journal of Medicine (2024 Aug 1;91(8):503-510).
Diabetic retinopathy is the leading cause of new cases of blindness in patients with diabetes mellitus.1–4 In 2020, more than 103 million individuals with diabetes mellitus worldwide were affected by diabetic retinopathy, and estimates suggest this number will increase to 160 million by 2045.5 Compared with all other leading causes of blindness, diabetic retinopathy is the only condition that has not experienced a decrease in age-standardized prevalence between 1990 and 2020.6
Without proper prevention and management, the burden of diabetic retinopathy will continue to grow, placing more patients at risk for complications that can cause severe vision loss, such as diabetic macular edema (DME) and proliferative diabetic retinopathy.
This article reviews the principles of screening for diabetic retinopathy, measures for preventing its development and progression, and current treatment options.
Diabetic retinopathy is classified as nonproliferative diabetic retinopathy (NPDR) and proliferative diabetic retinopathy based on the absence or presence of abnormal new blood vessels growing in the retina. The nonproliferative and proliferative stages are sequential. NPDR is further classified by severity as mild, moderate or severe, and proliferative diabetic retinopathy as early or high-risk.7
DME, defined as thickening of the retina, can occur in any stage of diabetic retinopathy and is the most common complication of diabetic retinopathy that causes vision loss.7,8 DME can be divided into center-involved DME, which is thickening in the center of the macula and has greater risk for vision loss, or noncenter-involved DME.8
Advertisement

Image content: This image is available to view online.
View image online (https://assets.clevelandclinic.org/transform/9622ac1d-6106-42cc-a6e3-a38872d932db/diabetic-macular-edema-inset)
Optical coherence tomography images demonstrate center-involved DME compared to a retina with no edema.
Patients with type 1 and type 2 diabetes, including children, are at increased risk for diabetic retinopathy. These patients should be screened regularly with a comprehensive eye examination because symptoms may not occur until the disease has advanced and sight is threatened.2,9,10 Although there are effective treatments to prevent progression to sight-threatening diabetic retinopathy, management is not possible until diabetic retinopathy has been detected. Unfortunately, screening rates remain low, with less than 50% of patients with diabetes mellitus receiving appropriate ophthalmic care through referrals from primary care physicians.3,11
The American Diabetes Association recommends referring patients with type 1 diabetes to an ophthalmologist or optometrist for an initial dilated and comprehensive eye examination within five years of onset. Patients with type 2 diabetes should be referred at the time of diagnosis.2,8 If any level of diabetic retinopathy is present on eye examination, the patient should receive dilated retinal examinations by an ophthalmologist or optometrist at least annually.2,8 If symptoms progress or sight is threatened, more frequent examinations are required. Conversely, if one or more annual eye examinations show no evidence of diabetic retinopathy and glycemic indicators are within goal range, eye examinations can take place every one to two years.2
Patients who have lowered their hemoglobin A1c (HbA1c) to less than 6.5% for at least three months while off glucose-lowering medications would be considered in remission for diabetes mellitus.12 With these patients, extending the screening intervals is acceptable, but it is important to adjust intervals based on the presence of other risk factors such as progression of diabetic retinopathy, advanced baseline retinopathy, uncontrolled hyperglycemia or diabetic macular edema.2
Advertisement
Pregnancy increases the risk for the development and progression of diabetic retinopathy. Patients with preexisting type 1 diabetes or type 2 diabetes who are planning pregnancy should undergo an eye examination before pregnancy, early in the first trimester and in the following trimesters, and up to one year postpartum, depending on the degree of diabetic retinopathy.2,11–13
According to the American Academy of Ophthalmology and the American Diabetes Association, patients who develop gestational diabetes mellitus do not require eye examinations.2,8
Retinal photography in the primary care setting with remote reading by an ophthalmologist, optometrist or artificial intelligence algorithms approved by the U.S. Food and Drug Administration can be used in patients without a history of diabetic retinopathy.2,14–16 This approach can increase access to diabetic retinopathy screening. However, retinal images must be of sufficient quality, and retinal photographs cannot substitute for follow-up eye examinations once abnormalities are detected.2
Artificial intelligence algorithms have specific exclusion criteria and provide limited results. The algorithms have not been used to screen patients with diabetes mellitus who are pregnant or who have blurred vision or floaters. Also, artificial intelligence algorithms are limited to detecting whether the eye is negative or positive for “more than mild” diabetic retinopathy.17,18 Consequently, if the screening is positive, an in-person eye examination by an ophthalmologist is required.
Advertisement
Sensitivity of artificial intelligence platforms for detecting diabetic retinopathy is greater than 87%, and specificity is greater than 88%.15,17,19 With high sensitivity and greater convenience, artificial intelligence platforms can increase the likelihood that patients with signs of diabetic retinopathy will receive a referral to ophthalmology, reducing the screening burden. The cost of hardware and services that come with these platforms is a consideration for primary care practices and may be a barrier to implementing these systems.18 However, remote interpretation by ophthalmologists, optometrists or an artificial intelligence algorithm increases screening rates and provides higher sensitivity and accuracy in detecting diabetic retinopathy than fundoscopic examination done in the primary care setting.11,20,21
Diabetic retinopathy is associated with major systemic complications of diabetes. Its presence and severity have been shown to predict stroke, myocardial infarction and death.22–25 Diabetic retinopathy is associated with the risk of diabetic nephropathy and diabetic neuropathy as well, and hence can be used to predict the development and progression of these conditions.26,27 Primary care physicians can help decrease the risk of diabetes complications by referring patients for comprehensive eye examinations and managing associated comorbidities.
Risk factors associated with diabetic retinopathy development and progression include hyperglycemia, dyslipidemia and high blood pressure. Strict glycemic control has been established as absolutely key in preventing diabetic retinopathy progression, but evidence is mixed for targeting dyslipidemia and high blood pressure as measures specifically to prevent or slow the progression of diabetic retinopathy.
Advertisement
Strict control of hyperglycemia is essential in minimizing the risk of diabetic retinopathy development or progression.1,28 The Diabetes Control and Complications Trial reported a strong relationship between risk of diabetic retinopathy and mean HbA1c. A decrease of about 10% in HbA1c resulted in a 39% decrease in risk of diabetic retinopathy progression.8 Long-term follow-up also showed that strict blood glucose control decreased the incidence of progression in severe NPDR, proliferative diabetic retinopathy and clinically significant macular edema.29
Elevated serum cholesterol and triglyceride levels have been implicated as risk factors for diabetic retinopathy. However, studies of the effect of statin and fibrate treatment specifically on diabetic retinopathy development and progression have produced mixed results.
The Action to Control Cardiovascular Risk in Diabetes (ACCORD) trial30 investigated intensive glycemic control and treatment of dyslipidemia in patients with type 2 diabetes (median baseline values for the dyslipidemia group were high-density lipoprotein cholesterol of 38 mg/dL, low-density lipoprotein cholesterol 93 mg/dL and triglycerides 162 mg/dL). After four years of follow-up, the study reported reduced rates of diabetic retinopathy progression with intensive glycemic control combined with fenofibrate and simvastatin treatment versus simvastatin plus placebo.
The Fenofibrate Intervention and Event Lowering in Diabetes (FIELD) study31 reported a decreased need for laser treatment in patients with diabetic retinopathy treated with fenofibrate. Other studies reported that statin therapy decreased the risk and incidence of diabetic retinopathy,4,32 while others found that statins do not protect against diabetic retinopathy progression.33–35
Despite the uncertainty about the effect of statin and fibrate therapy on diabetic retinopathy outcomes, multiple trials have shown the benefits of statin therapy and lipid control for overall management of diabetes mellitus, including a decreased risk for atherosclerotic cardiovascular disease events, coronary heart disease deaths and all-cause mortality.36
The role of blood pressure management in the prevention of diabetic retinopathy has been explored. A Cochrane review showed that although intensive blood pressure control was associated with a reduced risk of diabetic retinopathy development, it did not significantly impact progression of existing diabetic retinopathy compared with less stringent measures of blood pressure control.37
Although glycemic control with insulin or pharmacologic therapies is critical, the evidence is mixed on the effect of glucagon-like peptide-1 (GLP-1) receptor agonists on risk for diabetic retinopathy. Some meta-analyses and trials reported an increased risk of diabetic retinopathy with certain GLP-1 receptor agonists,38–44 while others reported no significant difference.45–49 Interestingly, many trials that reported an increased risk included or exclusively studied semaglutide, and many of the studies that found no significant difference reported on other GLP-1 receptor agonists. Furthermore, the increased risk for diabetic retinopathy seems to occur early in treatment and be transient, ranging from three months to three years after starting a GLP-1 receptor agonist, while the duration of improvement in retinopathy attributable to glycemic control ranges from about three years to more than five years.42,50
A plausible explanation for the potential early increased risk of diabetic retinopathy with GLP-1 receptor agonists is the drastic decrease in HbA1c that occurs when intensively managing diabetes mellitus, a phenomenon that may not necessarily be intrinsic to GLP-1 receptor agonists.50–52 In a multicenter, randomized clinical trial (Diabetes Control and Complications Trial), the risk of early worsening of diabetic retinopathy was greater in the intensive insulin treatment group compared with the conventional insulin treatment group among patients with type 1 diabetes.50 Interestingly, statistical analysis showed that the magnitude — but not the rapidity — of reduction in HbA1c was a significant risk factor for early worsening of diabetic retinopathy in the first six months of intensive treatment.50
A retrospective case-control study reported similar results, with a significant association between large reductions in HbA1c and worsening diabetic retinopathy in patients with uncontrolled type 2 diabetes.53 Further investigations of drastic reductions in HbA1c, specific pharmacotherapies and other glucose-lowering treatments such as bariatric surgery are needed to characterize early worsening of diabetic retinopathy and guide the safe management of diabetic retinopathy.
Nevertheless, GLP-1 receptor agonists have clear benefits in weight loss and cardiovascular risk, hypoglycemic risk and kidney risk management for patients with diabetes mellitus.38 When weighing the risks and benefits of a GLP-1 receptor agonist, the possible increased risk of development or progression of diabetic retinopathy should be carefully considered, especially if patients have a history of diabetic retinopathy or are already taking other diabetes medications that lower blood glucose. Primary care physicians should prioritize management of diabetes mellitus with a target HbA1c of 7% or lower while being mindful of large reductions of HbA1c when starting diabetes medications such as GLP-1 receptor agonists.8
Additional studies of GLP-1 receptor agonists with longer follow-up and primary end points for diabetic retinopathy risk assessment are needed. When considering GLP-1 receptor agonists, retinopathy status should be assessed by an ophthalmologist because of the potential initial worsening of retinopathy.
As with any progression of diabetic retinopathy, patients who experience worsening symptoms or signs of diabetic retinopathy in the context of rapid HbA1c reduction from diabetes medications such as GLP-1 receptor agonists should be seen by an ophthalmologist as soon as possible to assess the severity of progression and presence of any complications.2,8 These complications should be evaluated to determine their impact on next possible steps in management, such as observation, discontinuation of medications, anti-vascular endothelial growth factor (VEGF) injections, intravitreal corticosteroid injections or surgery.
Management of patients with diabetic retinopathy depends on the severity of the retinopathy and whether DME is present.8 Patients with mild, moderate or severe NPDR have a 15.6%, 44.6% and 62.6% chance of developing DME, respectively.54 Owing to the risk of developing complications, follow-up examinations are recommended every six to 12 months for those with mild to moderate NPDR and every two to four months for patients with severe NPDR and nonhigh-risk proliferative diabetic retinopathy.8
Standard treatment of diabetic retinopathy is anti-VEGF injections, which are used as off-label or U.S. Food and Drug Administration–approved treatment for all stages of diabetic retinopathy.8,55
NPDR. The American Academy of Ophthalmology Preferred Practice Pattern regarding patients with diabetic retinopathy and no DME recommends considering anti-VEGF only in patients with severe NPDR.8 However, recent studies have shown benefit in patients with milder disease. PANORAMA (Study of the Efficacy and Safety of Intravitreal Aflibercept for the Improvement of Moderately Severe to Severe Non-proliferative Diabetic Retinopathy)56 and the Diabetic Retinopathy Clinical Research Retina Network Protocol W57 looked at patients with moderate to severe NPDR and moderately severe to severe NPDR, respectively, both without DME. In these studies, patients treated with anti-VEGF injections had similar vision acuity outcomes compared with sham but a reduced risk of progression to proliferative diabetic retinopathy and development of center-involved DME.
Of U.S. retina specialists treating very severe NPDR without DME, 60% closely monitor the condition and encourage systemic glycemic control, 25% consider anti-VEGF therapy in some patients with poor glycemic control, around 8% consider it in all or most patients, and 3% consider it in some patients with good glucose control and compliance.58,59 Additionally, among those treating patients with severe NPDR without clinically significant DME, 52% do not recommend anti-VEGF therapy; 39.1% said they would recommend it if extensive peripheral nonperfusion were present on fluorescein angiography, and 27.5% would recommend it if fellow eye pathology were present.60
Proliferative diabetic retinopathy. Clinical trials have evaluated visual acuity outcomes in patients with proliferative diabetic retinopathy treated with ranibizumab versus panretinal photocoagulation. Gross et al61 showed that anti-VEGF treatment is noninferior to photocoagulation in patients with and without DME, and Sivaprasad et al62 showed that anti-VEGF treatment is superior in patients without DME. However, physicians should assess patient adherence, as patients with proliferative diabetic retinopathy treated with panretinal photocoagulation who were lost to follow-up longer than six months had better anatomic and functional outcomes compared with those treated with anti-VEGF therapy.63
Most ophthalmologists treat patients with high-risk proliferative diabetic retinopathy and center-involved DME with both anti-VEGF therapy and laser. In a survey of U.S. retina specialists, 69.9% of respondents said that they would start anti-VEGF therapy and plan for concurrent or future panretinal photocoagulation; 26% said they would treat with anti-VEGF injections and later assess the need for panretinal photocoagulation.59
DME. First-line therapy for patients with DME is intravitreal anti-VEGF injections.8 The RISE and RIDE (Ranibizumab Injection in Subjects With Clinically Significant Macular Edema With Center Involvement Secondary to Diabetes Mellitus) trials showed that ranibizumab significantly improved vision in patients with DME and reduced diabetic retinopathy severity across all stages.64 Anti-VEGF treatment is initiated with monthly injections for three to six months.65 The Diabetic Retinopathy Clinical Research Retina Network Protocol V evaluated patients with center-involved DME and visual acuity of 20/25 or better. It found that these patients should be observed with follow-up every two to four months, as initial treatment with either aflibercept or laser did not result in significant vision improvements compared with observation.66
Owing to insurance and costs, most patients are first treated with bevacizumab and, after treatment failure is demonstrated, are switched to another anti-VEGF therapy.67 However, in the Diabetic Retinopathy Clinical Research Retina Network Protocol T trial comparing the efficacy of intravitreal aflibercept, bevacizumab and ranibizumab in center-involved DME, patients with a visual acuity of 20/50 or worse receiving bevacizumab had worse two-year visual acuity outcomes compared with those taking aflibercept.8 Protocol AC, a multicenter, randomized clinical trial at 54 U.S. clinical sites, showed that patients who first received bevacizumab and then switched to aflibercept due to nonresponse had noninferior two-year vision outcomes compared with those taking aflibercept only.67,68
The efficacy of fixed-dose anti-VEGF regimens has been shown in clinical trials, but most clinicians use an as-needed or treat-and-extend approach to reduce treatment burden.69 Patients on the treat-and-extend treatment regimen are administered anti-VEGF at each visit, and the intervals between appointments are extended, maintained or decreased based on the presence of macular edema, as determined by optical coherence tomography imaging.70 Treat-and-extend has been shown to have similar vision and anatomic outcomes compared with as-needed or fixed-dose regimens in patients with center-involved DME, with treat-and-extend requiring significantly fewer injections compared with fixed dosing.70,71
Extended treatment intervals can be used with other anti-VEGF agents that have received U.S. Food and Drug Administration approval for treatment of center-involved DME.72,73 In the double-masked 96-week PHOTON (Study of a High-Dose Aflibercept in Participants With Diabetic Eye Disease) trial,74 patients with center-involved DME were randomized to receive aflibercept 8 mg every 12 or 16 weeks after three monthly doses or aflibercept 2 mg every 8 weeks after five monthly doses. Aflibercept 8 mg provided noninferior outcomes with fewer injections. In the YOSEMITE and RHINE (Efficacy and Safety of Faricimab in Participants With Diabetic Macular Edema) trials, faricimab also had extended durability in treating patients with center-involved DME.75
Laser is used as both primary and adjunctive treatment of diabetic retinopathy and DME. Multiple studies have demonstrated anti-VEGFs to be more effective than focal laser photocoagulation in improving visual acuity in patients with center-involved DME.8,76–79 In a survey of U.S. retina specialists treating patients with clinically significant DME on anti-VEGF therapy, 59.2% treated less than 5% of patients with focal or grid laser, and 21.7% treated 5% to 10% of patients with focal or grid laser.76 The American Academy of Ophthalmology Preferred Practice Pattern clinical guidelines advocate for focal or grid laser as the preferred treatment modality for noncenter-involved DME, citing lack of research on this specific pathology.8 Despite these guidelines, ongoing debate continues regarding the role of laser therapy in preventing vision loss.77,78
Intravitreally injected steroids are effective in treating DME, with visual acuity gains similar to anti-VEGF treatment.79 However, because of the risk of elevated intraocular pressure and cataract progression, intravitreal steroids are second-line therapies.8,79
Clinicians managing patients with diabetes mellitus must recognize the risks and complications associated with diabetic retinopathy and ensure that proper screening and referral processes are in place. Technological advancements like retinal photography with remote interpretation can reduce the burden of screening for diabetic retinopathy, but there are device and service costs. Furthermore, awareness of advances in diabetes medications, which effectively control blood glucose levels and subsequently prevent diabetic retinopathy and its direct and related complications, is essential.
The treatment of diabetic retinopathy and DME primarily involves anti-VEGF therapy. This therapy, while being the standard of care, may impose a significant treatment burden on patients. Therefore, it is imperative for clinicians to leverage new tools for early detection and new medications for effective management of diabetes and diabetic retinopathy.
For disclosures and a list of references, see the original article in Cleveland Clinic Journal of Medicine (2024 Aug 1;91(8):503-510).
Dr. Singh is a vitreoretinal surgeon at Cleveland Clinic. He also is Vice President and Chief Medical Officer of Cleveland Clinic Martin Hospitals in Florida. Dr. Das was a research fellow at Cleveland Clinic Cole Eye Institute. Chong is a medical student at Case Western Reserve University School of Medicine.
Advertisement
New service for patients with diabetes will make annual screening more convenient
Retrospective analysis finds lower mortality rates, fewer hospital visits among patients with Type 1 diabetes using GLP-1 Therapies
Association revises criteria for the diagnosis and resolution of severe conditions
What to consider in the management of euglycemic DKA
Familiarity will enhance its accessibility for patients with diabetes
New study counters earlier findings linking drugs with eye disease
Study highlights the value of quantitative ultra-widefield angiography
Longevity in healthcare, personal experiences may provide caregivers with false sense of confidence